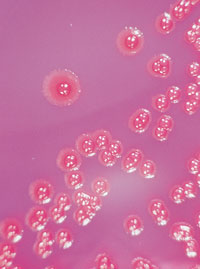

Between 5% and 10% of patients admitted to hospital acquire an infection during their admission. In Australia, the 1984 National Nosocomial Prevalence Survey documented that 6.3% of 28 643 hospitalised patients had a hospital-acquired infection, with the highest rates in larger hospitals.1 No similar study has been conducted since, but more recent data from the United States suggest that the rate of hospital-acquired infections has increased over the past two decades.2 The recent trend to shorter hospital stays means that more patients with hospital-acquired infections are presenting to general practitioners in the community. In addition, as home administration of intravenous medications becomes increasingly common, cannula-associated infections once confined to hospital patients may present in the community.
The impact of hospital-acquired infections is considerable: the patient may need longer hospital treatment, readmission, or even further surgery, increasing time off work and use of hospital and community resources. A recent Australian study reported that a surgical wound infection after coronary artery bypass graft (CABG) surgery added an average A$12 419 to the cost of CABG without this complication. If the infection was a deep sternal wound infection, then the extra cost was A$31 597.3
Many organisms gain entry to the body through breaches or evasion of "first line" body defences. Breaches in epithelial integrity (eg, surgical wounds, intravascular cannulas and drain tubes), loss of the washing action of body fluids (eg, because of a urinary catheter), and interference with first-line respiratory defences (eg, by anaesthesia and endotracheal intubation) are common precursors of hospital-acquired infections. Common sources and means of transmission of specific hospital-acquired organisms are summarised in Box 1.
Infections are also common among residents of long-term care facilities, such as nursing homes, special accommodation facilities and rehabilitation hospitals. Predisposing factors include intrinsic patient factors (eg, age and chronic medical conditions), presence of indwelling catheters, close communal living, immobility, incontinence, and frequent transfers back and forth between acute hospitals and the care facility. Urinary and respiratory tract infections and gastroenteritis are common, and outbreaks of scabies have been described. Influenza outbreaks in long-term care facilities may be prevented by ensuring residents undergo annual vaccination.
Hospital-acquired infections cover a wide spectrum, including septicaemia and respiratory tract infections. Common hospital-acquired infections that may present to community practitioners are those associated with urinary catheters and intravenous cannulas, and surgical wound infections.
These infections are common and may manifest when the catheter is in place or after its removal. The catheter causes urethral trauma and provides an extra- and intraluminal pathway to the bladder, while its manipulation, including disconnection, allows microorganism entry. Duration of catheterisation is the most important predictor of catheter-associated bacteriuria. Catheter obstruction in the presence of infected urine may result in septicaemia.
A patient who develops infection while the catheter is in place may complain of urethral discomfort, frequency, fever and pericatheter discharge. Infection occurring after catheter removal causes the usual symptoms of urinary tract infection. The causative organisms include those that are usual in urinary tract infection (eg, Escherichia coli), as well as hospital-acquired organisms (eg, methicillin-resistant Staphylococcus aureus [MRSA] and antibiotic-resistant gram-negative bacilli).
The presence of asymptomatic catheter-associated bacteriuria should not generally indicate a need for antimicrobial therapy. Possible exceptions include immunocompromised patients and patients undergoing urological surgery. Asymptomatic catheter-associated candiduria often reflects vaginal or gastrointestinal carriage.
When symptoms are present, the catheter should be removed if possible, a urine sample sent for culture, and a short course of antibiotic therapy given. If the urinary catheter must be kept in place then antibiotic therapy may relieve the symptoms, but the organism is likely to persist. Prolonged antibiotic therapy in the presence of an indwelling catheter will result in the emergence of antibiotic-resistant organisms.
Measures to prevent catheter-associated infections include:
The presence of an intravenous cannula can result in localised or systemic sepsis. In an Australian study, systemic sepsis occurred for 0.36 of every 1000 peripheral catheters used, and for 23 of every 1000 central vein catheters.4
The causative organisms originate from skin flora: either patients' own flora (eg, coagulase-negative staphylococci) or that acquired from hospital organisms (eg, MRSA). Skin microorganisms can adhere to the cannula and gain entry into tissues and, less commonly, the circulation, causing bacteraemia. Localised phlebitis with pain, tenderness, redness or pus at the site, or systemic sepsis with fever or hypotension, may result.
These clinical features arise most commonly while the cannula is in place, but may occur after its removal and patient discharge from hospital. Patients who are receiving home therapy with intravenous antibiotics may also present to their general practitioners during treatment.
If a patient develops signs of phlebitis, then the intravenous cannula should be removed, a swab should be taken of any purulent discharge for culture, and, if fever is present, blood should be cultured (case report, Box 2). Removal of the cannula and oral antistaphylococcal antibiotic therapy (eg, dicloxacillin) usually result in resolution of symptoms and signs. If local signs or fever persist, then further investigation and management should be considered (eg, blood cultures, ultrasound examination to detect a pus collection which may require surgical drainage and intravenous antibiotic therapy).
Non-infective complications, such as phlebitis or catheter-associated thrombosis, may mimic localised infection. If central-line-associated thrombosis is suspected, then a Doppler ultrasound examination should be considered.
Measures to prevent cannula-associated infection include:
use of aseptic cannula insertion technique;
minimising duration of cannulation;
regular examination for redness, pain, tenderness or purulence and, if detected, removal of the cannula.
change or removal of peripheral intravenous cannulas every 48–72 hours, as the risk of phlebitis is high after this time. Long central catheters (eg, peripherally inserted central catheters) do not need routine replacement.
Surgical wound infections occur in up to 10% of patients undergoing clean surgery, with the incidence varying with complexity of surgery, intrinsic patient risk and surgical skills. Most surgical wound infections result from contamination of the surgical wound with the patient's own flora or that of operating-room personnel or environment at the time of the surgery. Postoperative haematogenous seeding of the wound site is uncommon.
Infection may present clinically during hospitalisation. However, the current trend to shorter postoperative stays and day surgery result in more than 50% of surgical wound infections becoming apparent after discharge from hospital (case report, Box 3).5 Clinical infection may occur up to four weeks after deep surgery (eg, CABG) and up to 12 months after surgery involving an implanted prosthesis (eg, joint replacement).
The common clinical features of surgical wound infection are localised pain, redness and discharge. Fever that occurs within four weeks of surgery, without other localising features, is likely to be caused by infection at the surgical site. Superficial wound infection may resolve with or without antibiotics. Deeper or organ-space infection may require imaging for diagnosis, surgical drainage and antimicrobial therapy guided by culture of purulent material.
The likely causative organisms depend on the location and type of surgery. Most common is S. aureus, with MRSA common in some hospitals. For gastrointestinal or genitourinary tract surgery, gram-negative bacilli (eg, E. coli) are more common causes of infection.
A general practitioner should consider the following steps for a surgical wound infection presenting after hospital discharge:
swab wound discharge for microscopy and culture;
perform full examination and culture of blood if fever is present;
commence a course of antistaphylococcal antibiotic therapy (eg, dicloxacillin); and
notify and discuss with surgeon.
Strategies shown to decrease the risk of surgical wound infection include antibiotic prophylaxis, short preoperative hospital stay, optimisation of patient's risk factors (eg, diabetes control), and surveillance of surgical-site infections with feedback to the operating teams.
The organisms that cause hospital-acquired infections usually originate from the patient's own microbial flora, which may be altered by the addition of hospital-based organisms. The causative organisms cover a spectrum, with the relative importance of individual species varying over time, between units and hospitals, and between countries.
In Australia, MRSA has been a major hospital-acquired pathogen since the 1980s, especially in the larger tertiary hospitals. In some hospitals, more than 50% of S. aureus isolates are resistant to methicillin. These isolates are usually resistant to multiple antibiotic classes in addition to methicillin (ie, flucloxacillin and dicloxacillin). MRSA is a common cause of hospital-acquired bacteraemia, surgical wound infection and catheter-related sepsis. These infections generally require at least initial treatment with a glycopeptide antibiotic, such as vancomycin. Methicillin resistance also occurs in Staphylococcus epidermidis (MRSE), which is associated with infections of intravenous devices, renal dialysis catheters and orthopaedic prostheses.
The selective pressure generated by antibiotic use has led to the development of new antibiotic-resistant hospital microorganisms (Box 4). These new and emerging pathogens have several features in common: they are resistant to commonly used classes of antibiotics, and they cause both endemic and epidemic hospital outbreaks, resulting in significant patient morbidity and mortality. There is also concern that these organisms may spread from hospitals into the general community, as evidence suggests MRSA has done, especially into long-term care facilities such as nursing homes.
Up to a third of hospital-acquired infections are preventable.10 The two main arms of prevention are stopping the development of antibiotic resistance and preventing the spread of resistant organisms between patients.
Antibiotic use selects for antibiotic-resistant organisms. Minimising this selective pressure requires continuing education or re-education of prescribers, their adherence to agreed policies and practices, and ideally involvement in ongoing surveillance of antibiotic use and antibiotic resistance patterns. Some common practices, such as use of broader — rather than narrow — spectrum antimicrobials, need to be reversed.
The widespread use of antibiotics in animal husbandry and potential transmission of antibiotic-resistant organisms to humans is also of increasing concern. The common use of avoparcin as a growth promoter in animal husbandry and its possible role in the development of vancomycin-resistant enterococci (VRE) in humans has led to withdrawal of this antibiotic from veterinary use. Recently, veterinary and other use of antimicrobial agents has been critically examined in Australia by the Joint Expert Technical Advisory Committee on Antibiotic Resistance (JETACAR), with subsequent recommendations on areas such as regulatory controls, monitoring and surveillance and infection prevention strategies and hygiene measures.11
Many of the principles for preventing spread of hospital-acquired organisms are well known. There is no single successful recipe, and the approach for individual hospitals must be based on the epidemiology of the organism and the resources available. Important ingredients of a program to prevent hospital-acquired infections are summarised in Box 5, illustrating the breadth of such prevention programs. Staff should use preventive measures at all times, not only for patients considered "infectious".
The cornerstone of successful hospital infection control is surveillance. This includes prospective collection of high quality data, their analysis, and timely feedback to healthcare practitioners. To achieve this, hospital surveillance systems need to be prospective, targeted and risk-adjusted, to use validated definitions and methods, and to be open to valid interhospital comparison. Effective surveillance for hospital-acquired infection is an example of quality improvement: a problem is identified by surveillance (eg, peripheral intravenous line sepsis), the data can suggest an intervention (eg, automatic removal of intravenous cannulas at 48 hours), and ongoing surveillance documents the effectiveness of that intervention.
Recently developed Australian surveillance projects aim to allow valid comparison of rates of specific hospital-acquired infections between hospitals. The Victorian Infection Control Surveillance Project (VICSP) has achieved this aim, with each participating hospital accepting standardised methods and definitions. VICSP has reported comparative interhospital surgical-site infection rates for CABG and total knee and hip replacement surgery.13 In New South Wales, the Hospital Infection Standardised Surveillance (HISS) program has also reported data across hospitals.14
A further recent advance in hospital infection surveillance is the use of molecular methods to identify and type organisms, thereby clarifying the clonal or polyclonal nature of apparent outbreaks. Findings can then direct infection control practices.2 Molecular testing has confirmed that some apparently "endemic" infections (eg, MRSA infections) are in fact a series of mini-outbreaks. Each outbreak arises when a single breach in infection control practice transmits an organism to one or a small number of patients.2
Surveillance systems need to evolve with changes in the healthcare system. Early hospital discharge after surgery means that surveillance for inpatient surgical wound infections may need to be supplemented by post-discharge surveillance. Similarly, infections that occur in the "hospital in the home" or home nursing setting may need to be considered in surveillance systems.
There is an ongoing need for surveillance programs to identify individual risk factors that contribute to specific hospital-acquired infections. For example, diabetes and obesity have recently been demonstrated to be independent predictors of surgical-site infection in CABG surgery.15 Such findings may direct interventions to decrease incidence of this infection.
All patient-care staff, in both hospitals and the community, have a role in day-to-day surveillance. Events such as an unexpected case or concern about poor infection control practice should be discussed with infection control staff.
In the 21st century, the specialty of infection control requires a breadth of expertise that no sole practitioner can possess. A multidisciplinary team is needed, including infection control practitioners, a hospital epidemiologist, biostatistician, infectious diseases physician and microbiologist, as well as access to a molecular biology laboratory. The effectiveness of such a team was demonstrated recently in a 683-bed hospital in the United States; an "enhanced, integrated infection control program" with access to a molecular typing laboratory decreased hospital-acquired infections per 1000 patient-days by over 10%, with an actual cost saving over two years of US$4.3 million.2
The challenge for hospital and community practitioners today is to prevent hospital-acquired and other healthcare-associated infections in a continually changing medical environment, with increasing numbers of immunocompromised patients, increasingly complex medical procedures and increasing antibiotic-resistant organisms. To meet the challenge, Australia has two major needs: the development of academic infection control departments within Australian hospitals for the study and prevention of hospital-acquired infections, and a national surveillance system for hospital-acquired infection incorporating validated methods.
Evidence-based recommendations
An effective hospital infection control program, including an infection control practitioner, active surveillance with feedback, and an infectious disease physician, can reduce incidence of hospital-acquired infections10 (E31).
Collection and collation of surgical wound infection rates, together with feedback to relevant staff, reduces incidence of surgical wound infections16 (E4).
Some infections which appear common or "endemic" in hospitals (eg, methicillin-resistant Staphylococcus aureus) result from a number of mini-outbreaks or breaches in good infection control practice. Molecular typing methods to identify the clonality of such organisms can guide infection control strategy, with subsequent decrease in hospital-acquired infections2 (E33).
Short peripheral venous cannulas should be replaced every 48–72 hours to minimise the risk of phlebitis and cannula-associated sepsis. Central venous catheters do not require routine replacement17 (E33).
Improved compliance with appropriate handwashing and hand-disinfection protocols can reduce incidence of hospital-acquired infection18 (E33).
1: Sources and transmission of hospital-acquired organisms
Source |
Transmission |
Organism |
|||||||||
Microbial flora of colonised or infected patients (less commonly, persistently colonised or infected staff) |
Direct contact via staff hands and devices |
Methicillin-resistant Staphylococcus aureus |
|||||||||
Inanimate hospital environment |
Direct contact via staff hands |
Methicillin-resistant Staphylococcus aureus | |||||||||
Hospital equipment |
Inadequately disinfected endoscope |
Hepatitis C virus, Mycobacterium tuberculosis and other mycobacteria |
|||||||||
Infected patient or staff member |
Respiratory droplet or nuclei |
Influenza virus, varicella virus, M. tuberculosis |
|||||||||
Infected patient or staff member |
Bloodborne |
HIV, hepatitis B and C viruses |
|||||||||
3: Case report — surgical wound infection
![]() Swab of pus, showing white blood cells and gram-positive cocci in clumps typical of staphylococci (Gram stain; original magnification, x 1000). |
History: A 72-year-old man was admitted to hospital on the morning of planned coronary artery bypass graft surgery. He had a history of cigarette use and diabetes, and was 10 kg overweight. The surgery was uncomplicated, and he was discharged on the eighth postoperative day. A week later, he presented to his general practitioner with fever and pain over the sternal wound. Investigations: Clinical examination revealed fever (38°C) and tender erythema over the lower half of the sternal wound. There was no evidence of infection at the saphenous-vein harvest graft site. Management: The general practitioner took blood for full blood examination and culture and referred the patient back to the cardiothoracic surgeon. He was readmitted, and given intravenous cephazolin for a sternal wound infection. Further investigation and management: Despite antibiotic therapy, his symptoms worsened and on the third hospital day the sternal wound discharged a large quantity of pus. The infection required formal surgical drainage with debridement of sternal osteomyelitis and a four-week course of intravenous vancomycin for infection with methicillin-resistant Staphylococcus aureus (MRSA). |
Strategies that may have decreased the risk of surgical wound infection include:
|
4: New and emerging antibiotic-resistant pathogens
![]() |
←Vancomycin-resistant enterococci (VRE): This organism was first described in Australia in 1994. In some countries, it has spread rapidly to many hospitals, especially intensive care and renal units. In most situations, enterococcus has low virulence, but it can be a significant pathogen, especially in debilitated or immunocompromised patients. Some VRE strains are untreatable with currently available antibiotics. Image: Enterococcal colonies on bile–aesculin agar; black colour change is due to aesculin hydrolysis. Vancomycin-intermediate Staphylococcus aureus (VISA): The appearance of S. aureus with reduced susceptibility to vancomycin in Japan, the United States, Europe8 and now Australia9 is a recent, frightening development. Image: Gram stain of staphylococci (original magnification, x 400). → |
![]() |
![]() |
←Multiply antibiotic-resistant gram-negative organisms: These include Acinetobacter spp., Enterobacter spp. and Klebsiella pneumoniae with extended-spectrum β-lactamases (ESBLs). These organisms give rise to both endemic and epidemic hospital-acquired infections. Many are resistant not only to the newer third-generation cephalosporins, but also to other classes of antibiotics. Recently, there have been outbreaks of antimicrobial-resistant Acinetobacter spp. in Australian intensive care units.6,7 Image: Colonies of a gram-negative rod on MacConkey's agar. Multidrug-resistant Mycobacterium tuberculosis: The worldwide resurgence of tuberculosis, caused in part by the increasing incidence of multidrug-resistant M. tuberculosis, has included hospital outbreaks affecting both patients and healthcare workers. Image: Acid-fast stain of sputum with M. tuberculosis cells stained red (original magnification, x 400).→ |
![]() |
5: Components of a program to prevent hospital-acquired infection
Practitioner behaviour Compliance with handwashing protocols Use of aseptic technique for insertion of intravenous and urinary catheters Compliance with guidelines on antimicrobial use12 Patient care Short hospital stays Early removal of invasive devices Isolation of infectious patients Hospital infrastructure and policies Adequate staff numbers Staff vaccination (eg, hepatitis B, varicella–zoster, tuberculosis and influenza) Sharps policy Adequate sterilisation and disinfection of surgical instruments and endoscopes Infection control team Infection control program Active surveillance for hospital-acquired infection Molecular biology laboratory |
- Denis W Spelman1
- Series Editors:
- Alfred Hospital, Melbourne, VIC.
- 1. McLaws ML, Gold J, King K, et al. The prevalence of nosocomial and community-acquired infections in Australian hospitals. Med J Aust 1988; 149: 582-590.
- 2. Hacek DM, Suriano T, Noskin GA, et al. Medical and economic benefit of a comprehensive infection control program that includes routine determination of microbial clonality. Am J Clin Pathol 1999; 111: 647-654.
- 3. Jenney AW, Harrington GA, Russo PI, Spelman DW. The cost of surgical site infection following coronary artery bypass surgery. 2001; 71: 662-664.
- 4. Collignon PJ. Intravascular catheter associated sepsis: a common problem. Med J Aust 1994; 161: 374-378.
- 5. Mitchell DH, Swift G, Gilbert GL. Surgical wound infection surveillance: the importance of infections that develop after hospital discharge. Aust N Z J Surg 1999; 69: 117-120.
- 6. Mitchell DH, Dempsey KM, Jeffs PJ. Multiresistant Acinetobacter baumannii: description of an outbreak centred on an intensive care unit in an Australian hospital. Aust Infect Control 1999; 4: 12-15.
- 7. Inglis T. Acinectobacter in the intensive care unit. Aust Infect Control 1999; 4: 8-10.
- 8. Fridkin SK. Vancomycin-intermediate and -resistant Staphylococcus aureus: what the infectious disease specialist needs to know. Clin Infect Dis 2001; 32: 108-115.
- 9. Ward PB, Johnson PDR, Grabsch EA, et al. Treatment failure due to methicillin-resistant Staphylococcus aureus (MRSA) with reduced susceptibility to vancomycin. Med J Aust 2001; 175: 480-483. <eMJA full text>
- 10. Haley RW, Culver DH, White JW, et al. The efficacy of infection surveillance and control programs in preventing nosocomial infections in US hospitals. Am J Epidem 1985; 121: 182-185.
- 11. The Joint Expert Technical Advisory Committee on Antibiotic Resistance (JETACAR). The use of antibiotics in food-producing animals: antibiotic-resistant bacteria in animals and humans. Canberra: Office of National Health and Medical Research, Oct 1999. Available at <http://www.health.gov.au/internet/wcms/Publishing.nsf/Content/health-pubs-jetacar-cnt.htm> Accessed Aug 2005.
- 12. Therapeutic Guidelines Limited. Therapeutic guidelines: antibiotic. Version 11, 2000. Melbourne: Therapeutic Guidelines Limited, 2000.
- 13. Victorian Infection Control Surveillance Project (VICSP). Comparative surgical site infection rates and risk factor analysis in coronary artery bypass surgery and hip/knee replacement [abstract]. Proceedings of the Annual Scientific Meeting of the Australasian Society for Infectious Diseases. 2000 Apr 16-19; Leura NSW.
- 14. McLaws M, Murphy C, Whitby M. Standardising surveillance of nosocomial infections: The HISS Program. J Qual Clin Pract 2000; 20: 6-11.
- 15. Spelman D, Russo P, Harrington G, et al. Risk factors for surgical wound infection and bacteremia following coronary artery bypass surgery. Aust N Z J Surg 2000; 70: 47-51.
- 16. Olson MM, Lee JT. Continuous 10 year wound infection surveillance. Results, advantages and unanswered questions. Arch Surg 1990; 125: 794-803.
- 17. Pearson ML, Hospital Infection Control Practices Advisory Committee. Guideline for prevention of intra-vascular device related infections. Infect Control Hosp Epidemiol 1996; 17: 438-473.
- 18. Pittet D, Augonnet S, Harbath S, et al. Effectiveness of hospital wide programme to improve compliance with hand hygiene. Lancet 2000; 356: 1307-1312.

Abstract
About 6% of patients acquire an infection in hospital, and the incidence of hospital-acquired infections may be increasing.
Common hospital-acquired infections are respiratory and urinary tract infections, surgical wound infections and infections associated with intravascular cannulas.
The common hospital pathogens are methicillin-resistant Staphylococcus aureus, antibiotic-resistant gram-negative bacilli and, more recently, vancomycin-resistant enterococci.
Surveillance is the cornerstone of effective infection control and prevention of hospital-acquired infections.
Strategies to prevent both development of antibiotic resistance and spread of resistant organisms are necessary.
Preventive strategies include prudent antimicrobial use, timely handwashing, aseptic technique, short hospital stays, minimal use and early removal of invasive devices, adequate staffing and an active infection control program.
Sound infection control practice and prudent antibiotic use will reduce antimicrobial-resistant organisms and hospital-acquired infections